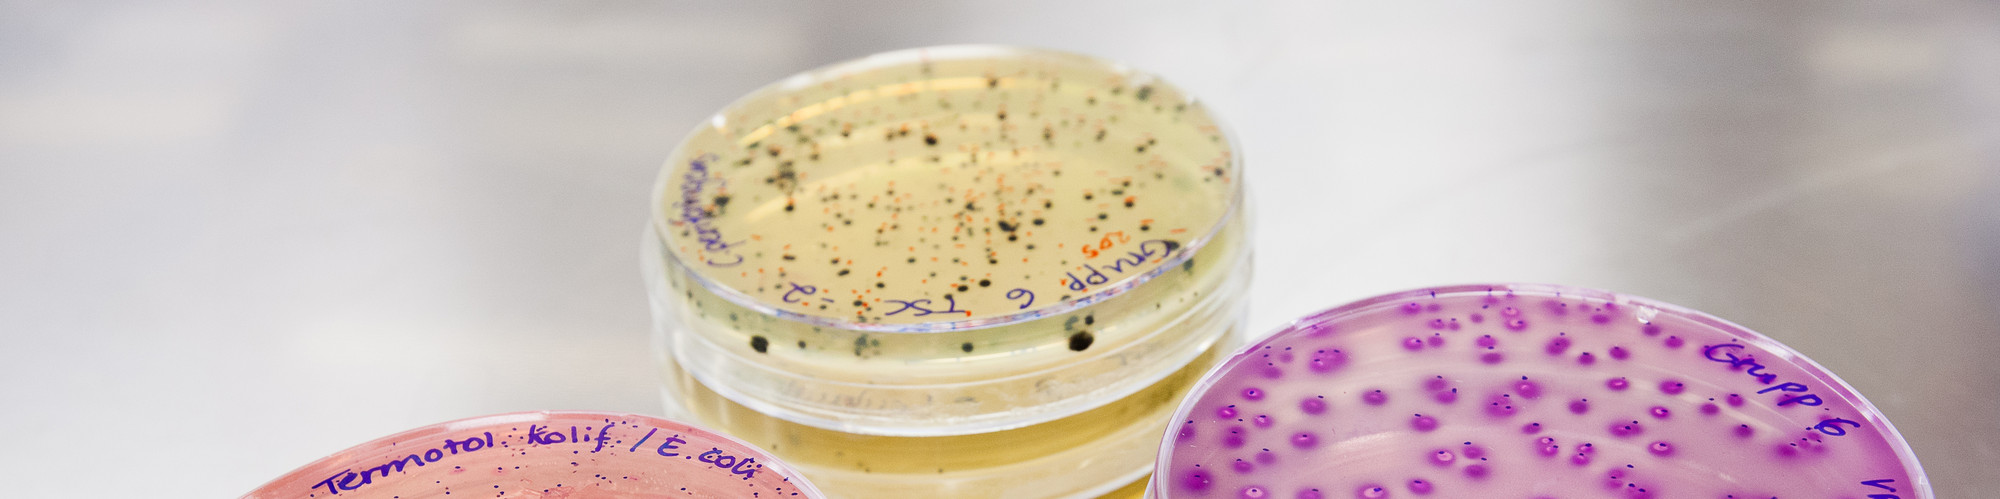
Petri dishes with bacterial culture. Photo.

Facts
City: Online
Organiser: NordCAW
Last signup date: 17 November 2020
Price: Free of charge
Additional info:
Margareta Stéen: margareta.steen@slu.se
Elina Åsbjer: elina.asbjer@slu.se
Online
NordCAW (Nordic Network for Communicating Animal Welfare) invites you to a seminar about animal welfare and its connection to the use of antibiotic and antibiotic resistance from a Nordic perspective.
Food produced from animals with poor welfare pose a serious threat to human health. The purpose of this symposium is to increase awareness and knowledge of the One Health concept and to show that animal welfare is closely linked to the use of antibiotics and antimicrobial resistance and thus human health.
Animal welfare and animal health affect the use of antibiotics in food production and thus the development of antimicrobial resistance (AMR). Animals that live under poor conditions become stressed and can suffer from and spread infectious diseases. The use of antibiotics will increase and with that the risk of antibiotic resistance will increase.
The Nordic and Baltic Animal Welfare Centers (NordCAW) want to be a strong voice for animal welfare and work to reduce the use of antibiotics in food production. We work in the “One Health perspective” with the aim of protecting the health and well-being of animals, people and the environment.
With the symposium, NordCAW wants to share and disseminate knowledge about the consequences of poor animal welfare for the development of AMR as well as sharing good examples of how to reduce the use of antibiotics.
Date: 24 November 2020
Time: 10.30 am to 5.30 pm
Place: Webinar on Zoom
Due to the situation with Covid-19 the seminar will only be available through live streaming.
Please follow this link to join the NordCAW seminar 2020:
https://slu-se.zoom.us/j/69855115171
Password: 370629
The seminar is only open to registered participants.
Margareta Stéen: margareta.steen@slu.se
Elina Åsbjer: elina.asbjer@slu.se
10.50 – 11.00 Welcome and introduction, Susanna Sternberg-Lewerin, SLU Future Animals, Nature and Health, Sweden
11.00 – 11.20 The Swedish model – a historic perspective, Gunnela Ståhle, Vi Konsumenter
11.20 – 11.40 Use of antibiotics for animals – why and why not?, Christina Greko, National Veterinary Institute, Sweden
11.40 – 11.50 SHORT BREAK
11.50 - 12.10 ESBL in chickens – spread in populations and between countries, Oskar Nilsson, National Veterinary Institute, Sweden
12.10 – 12.30 MRSA in pig production, Anders Rhod Larsen, Statens Serum Institut, Denmark
12.30 – 13.20 LUNCH
13.20 – 13.50 New EU legislation on medication for animal use – what are the implications for the NordCAW members and EU, Fredrik Hultén, Swedish Medical Products Agency
13.50 – 14.20 Raising pigs - health, welfare and antibiotics, Per Wallgren, National Veterinary Institute, Sweden
14.20 – 14.30 SHORT BREAK
14.30 - 14.45 Grazing and its connection to animal health, welfare and economics, Karin Alvåsen, Swedish University of Agricultural Sciences
14.45 – 15.15 Dairy Cows – health, welfare and antibiotics, Ylva Persson, National Veterinary Institute, Sweden
15.15 – 15.35 Consumer attitudes towards production diseases in intensive animal production, animal welfare and use of antibiotics, Jarkko Niemi, National Resources Institute Finland
15.35 – 16.00 COFFEE BREAK
16.00 – 16.20 Handling of MRSA-pigs in Norway, Anne Margrete Urdahl, Norwegian Veterinary Institute
16.20 – 16.40 Raising pigs without antibiotics, Poul Baekbo, SEGES; Danish Agriculture & Food Council
16.40 – 17.00 Naracin free broiler production, Magne Kaldhusdal, Norwegian Veterinary Institute
17.00 – 17.20 The Danish model, Elisabeth Okholm, The Danish Veterinary and Food Administration
17.20 -17.30 Closing, Susanna Sternberg-Lewerin, SLU Future Animals, Nature and Health, Sweden